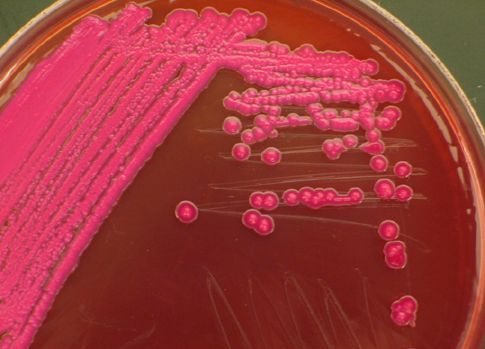
Σε όλο τον κόσμο εξαπλώνεται η νέα κατηγορία πολυανθεκτικών βακτηρίων

Μετά τις ομάδες αίματος, οι ομάδες «εντερότυπου»
Οι άνθρωποι μπορούν να χωριστούν σε τρεις κατηγορίες ανάλογα με τα βακτήρια που ζουν στο πεπτικό τους σύστημα, προτείνουν Ευρωπαίοι μοριακοί βιολόγοι. Εκτιμούν μάλιστα ότι στο μέλλον οι γιατροί θα μας ρωτούν για τον τύπο της εντερικής μας χλωρίδας, όπως μας ρωτούν για την ομάδα αίματος στην οποία ανήκουμε.

Αριθμός Πιστοποίησης Μ.Η.Τ.232442
Αριθμός Πιστοποίησης Μ.Η.Τ.232442